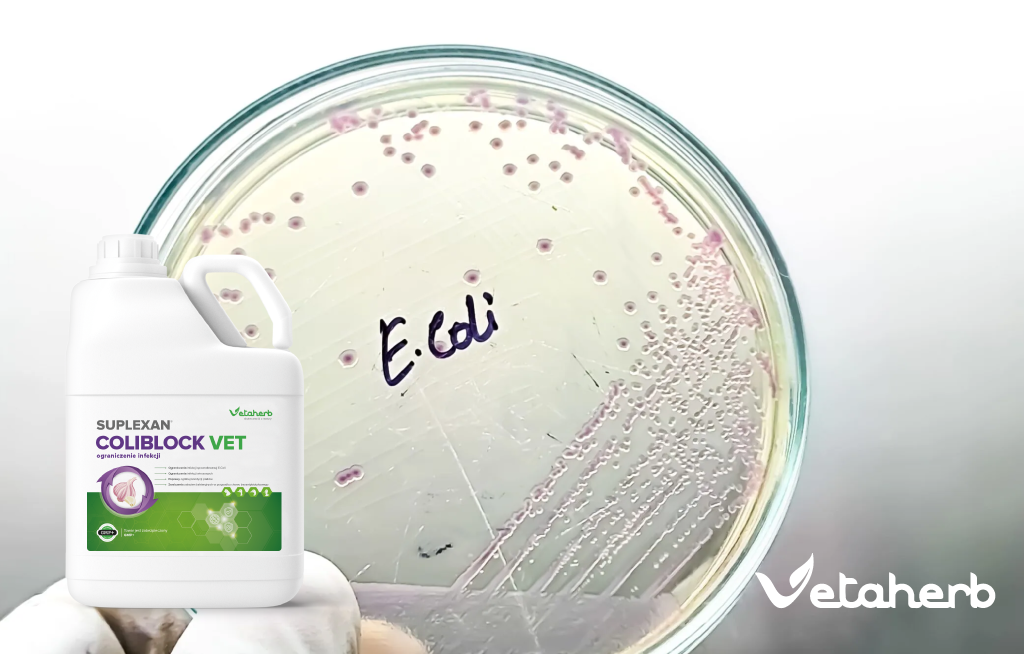
Kolibakterioza u kur – niebezpieczna bakteria E. coli

- 22 lutego, 2026
Tucz brojlerów bez antybiotyków
Tucz brojlerów bez antybiotyków jest możliwy do prowadzenia w sposób stabilny i opłacalny, ale wymaga podejścia programowego, w którym zdrowie jelit, jakość wody, mikroklimat i higiena środowiska są traktowane jako elementy pierwszoplanowe. W praktyce oznacza to, że wynik produkcyjny buduje …